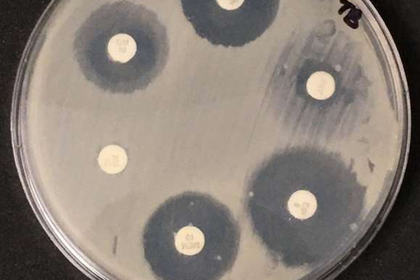
Названа неожиданная опасность уборки пыли

Названа неожиданная опасность уборки пыли
Названа неожиданная опасность уборки пыли
13 декабря 2018
Marishka
На печать
Ученые Северо-Западного университета (США) показали, что триклозан, содержащийся в чистящих средствах, вызывает устойчивость к антибиотикам у микроорганизмов, обитающих в пыли. Об этом сообщается в пресс-релизе на Phys.org.
Исследователи проанализировали образцы пыли, взятые на 42 спортивных сооружениях, где люди часто прикасаются к полу, матам и снарядам, а также используют антимикробные салфетки. Оказалось, что те пробы, что содержали большое количество триклозана, имели генетические маркеры устойчивости к антибиотикам со сходным механизмом действия.
Триклозан в США добавляли в средства дезинфекции до 2017 года, пока Управление по санитарному надзору за качеством пищевых продуктов и медикаментов (FDA) не запретило использовать это вещество при производстве антибактериального мыла из-за потенциального вреда для эндокринной и репродуктивной системы человека. Однако он до сих пор содержится в зубной пасте и других средствах личной гигиены.
В августе сообщалось, что австралийские ученые выяснили, что некоторые штаммы патогенных бактерий, резистентных к антибиотикам, стали устойчивы к дезинфицирующим веществам, содержащим спирт.
https://lenta.ru